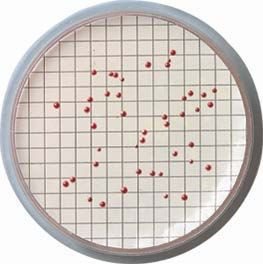

Sterlitech Mixed Cellulose Esters (MCE) Membrane Filters - A020H047A
Sterlitech Mixed Cellulose Esters (MCE) Membrane Filters utilize a mixture of cellulose nitrate and cellulose acetate to deliver superior flow rates with high protein binding affinity. These membranes are ideal for particle monitoring, manufacturing diagnostic kits, and microbiology applications.
MCE membrane filters exhibit a precise and uniform pore structure, consistent thickness, and a smoother surface than pure nitrocellulose membranes. They are the most common membrane used for microbial analyses, due to excellent retention and recovery characteristics. These membranes are designed for quick and easy identification of surface-retained particles. They are offered with a variety of custom features; white discs to observe changes in color, black discs to improve contrast with microorganisms, and gridded options in both colors for accurate quantification of microbial growth.
Applications
- Biological fluid sterilization and contamination testing
- Measuring Silt Density Index (SDI): ASTM D4189
- Particulate analyses of lubricating oils/hydraulic fluids
- Medical assays for drugs and pathogenic microorganism
- Substrate for lateral flow and capillary immunoassays
- Microbial observation with black-dyed membranes
- Bacterial enumeration with gridded membranes
Standard Methods for water testing:
- 9222 B (Total Coliforms)
- 9222 D and 9230 C (Fecal Coliforms)
- 9215 D (Total Bacteria)
- 9260 B (Salmonella)
- 9213 (Pseudomonas sp)
- 9213 E (Psedomonas aeruginosa)
3.0 µm, 5.0 µm and 8.0 µm pore sizes and black filters are also available.
You've got questions, we've got answers.
Reach out and let's see what we can do together.